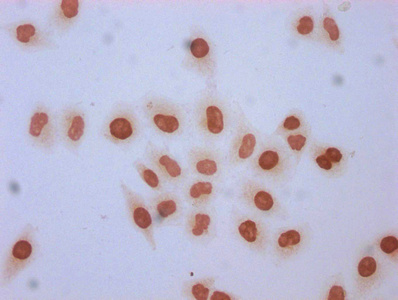

Formyl-HIST1H1C (K96) Antibody
-
中文名稱:Formyl-HIST1H1C (K96)兔多克隆抗體
-
貨號:CSB-PA010378OA96forHU
-
規格:¥660
-
圖片:
-
Western Blot
Detected samples: Hela whole cell lysate, 293 whole cell lysate, HepG2 whole cell lysate, A549 whole cell lysate; Untreated (-) or treated (+) with 30mM sodium butyrate for 4h
All lanes: HIST1H1C antibody at 1:500
Secondary
Goat polyclonal to rabbit IgG at 1/40000 dilution
Predicted band size: 22 kDa
Observed band size: 22 kDa -
Immunofluorescence staining of Hela cells with CSB-PA010378OA96forHU at 1:2.5, counter-stained with DAPI. The cells were fixed in 4% formaldehyde, permeabilized using 0.2% Triton X-100 and blocked in 10% normal Goat Serum. The cells were then incubated with the antibody overnight at 4°C. The secondary antibody was Alexa Fluor 488-congugated AffiniPure Goat Anti-Rabbit IgG(H+L).
-
Immunocytochemistry analysis of CSB-PA010378OA96forHU diluted at 1:5 and staining in Hela cells (treated with 30mM sodium butyrate for 4h) performed on a Leica BondTM system. The cells were fixed in 4% formaldehyde, permeabilized using 0.2% Triton X-100 and blocked with 10% normal goat serum 30min at RT. Then primary antibody (1% BSA) was incubated at 4°C overnight. The primary is detected by a biotinylated secondary antibody and visualized using an HRP conjugated SP system.
-
-
其他:
產品詳情
-
產品名稱:Rabbit anti-Homo sapiens (Human) HIST1H1C Polyclonal antibody
-
Uniprot No.:
-
基因名:
-
別名:H1 histone family member 2 antibody; H1.a antibody; H12_HUMAN antibody; H1F2 antibody; H1s-1 antibody; HIST1H1C antibody; Histone 1 H1c antibody; Histone cluster 1 H1c antibody; Histone H1.2 antibody; Histone H1c antibody; Histone H1d antibody; Histone H1s-1 antibody; MGC3992 antibody
-
宿主:Rabbit
-
反應種屬:Human
-
免疫原:Peptide sequence around site of Formyl-Lys (96) derived from Human Histone H1.2
-
免疫原種屬:Homo sapiens (Human)
-
標記方式:Non-conjugated
-
克隆類型:Polyclonal
-
抗體亞型:IgG
-
純化方式:Antigen Affinity Purified
-
濃度:It differs from different batches. Please contact us to confirm it.
-
保存緩沖液:Preservative: 0.03% Proclin 300
Constituents: 50% Glycerol, 0.01M PBS, pH 7.4 -
產品提供形式:Liquid
-
應用范圍:ELISA, WB, ICC, IF
-
推薦稀釋比:
Application Recommended Dilution WB 1:500-1:2000 ICC 1:1-1:10 IF 1:1-1:10 -
Protocols:
-
儲存條件:Upon receipt, store at -20°C or -80°C. Avoid repeated freeze.
-
貨期:Basically, we can dispatch the products out in 1-3 working days after receiving your orders. Delivery time maybe differs from different purchasing way or location, please kindly consult your local distributors for specific delivery time.
-
用途:For Research Use Only. Not for use in diagnostic or therapeutic procedures.
相關產品
靶點詳情
-
功能:Histone H1 protein binds to linker DNA between nucleosomes forming the macromolecular structure known as the chromatin fiber. Histones H1 are necessary for the condensation of nucleosome chains into higher-order structured fibers. Acts also as a regulator of individual gene transcription through chromatin remodeling, nucleosome spacing and DNA methylation.
-
基因功能參考文獻:
- results define a network of E2F target genes as susceptible to the regulatory influence of H1.2, where H1.2 augments global association of pRb with chromatin, enhances transcriptional repression by pRb, and facilitates pRb-dependent cell-cycle arrest PMID: 28614707
- BRG1 participates in gene repression by interacting with H1.2, facilitating its deposition and stabilizing nucleosome positioning around the transcription start site. PMID: 27390128
- Results show that histones H1.2 and H1.4 were observed in MDA-MB-231 metastatic breast cancer cells. The phosphorylation at S173 of histone H1.2 and S172, S187, T18, T146, and T154 of H1.4 significantly increases during M phase suggesting that these events are cell cycle-dependent. Also, the study reports the observation of the H1.2 SNP variant A18V in MCF-10A cells. PMID: 26209608
- Integration with apoptotic intermediates (via C-terminal tail interactions) may constitute a more generalized function of linker histone isoforms in apoptotic cascades. PMID: 24525734
- Histone H1.2-T165 post translational modifications are dispensable for chromatin binding and cell proliferation while the H1.4-K26 modifications are essential for proper cell cycle progression. PMID: 24873882
- H1.2 interacts with Cul4A and PAF1 to activate developmental regulatory genes. PMID: 24360965
- H1.2 is less abundant than other histone H1 variants at the transcription start sites of inactive genes, and promoters enriched in H1.2 are different from those enriched in other histone H1 variants and tend to be repressed. PMID: 24476918
- Mutations in linker histone genes HIST1H1 B, C, D, and E; OCT2 (POU2F2); IRF8; and ARID1A underlying the pathogenesis of follicular lymphoma. PMID: 24435047
- These data suggest that p53 acetylation-H1.2 phosphorylation cascade serves as a unique mechanism for triggering p53-dependent DNA damage response pathways. PMID: 22249259
- confirmed N-terminal acetylation on all isoforms plus a single internal acetylation site; phosphorylation sites were located on peptides containing the cyclin dependent kinase (CDK) consensus motif PMID: 15595731
- The binding of histone H1 to a general amyloid-like motif indicates that histone H1 may play an important common role in diseases associated with amyloid-like fibrils. PMID: 16854430
- Histone H1.2 was translocated from the nucleus to the mitochondria after treatment with bleomycin and co-localized with Bak in mitochondria. PMID: 17879944
- that the recruitment of YB1, PURalpha, and H1.2 to the p53 target gene Bax is required for repression of p53-induced transcription. PMID: 18258596
顯示更多
收起更多
-
亞細胞定位:Nucleus. Chromosome. Note=Mainly localizes in euchromatin. Distribution goes in parallel with DNA concentration.
-
蛋白家族:Histone H1/H5 family
-
數據庫鏈接:
Most popular with customers
-
-
YWHAB Recombinant Monoclonal Antibody
Applications: ELISA, WB, IHC, IF, FC
Species Reactivity: Human, Mouse, Rat
-
Phospho-YAP1 (S127) Recombinant Monoclonal Antibody
Applications: ELISA, WB, IHC
Species Reactivity: Human
-
-
-
-
-